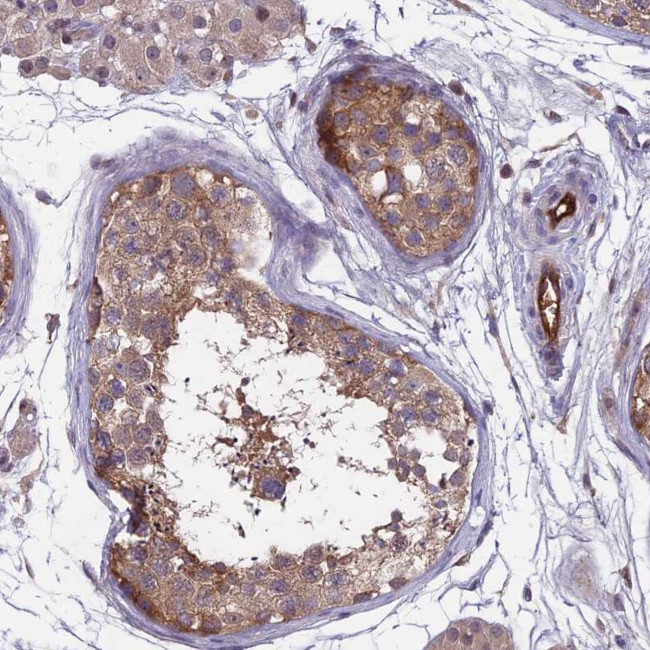
MAST2 Antibody in Immunohistochemistry (Paraffin) (IHC (P))

Search
Invitrogen
MAST2 Polyclonal Antibody
{{$productOrderCtrl.translations['antibody.pdp.commerceCard.promotion.promotions']}}
{{$productOrderCtrl.translations['antibody.pdp.commerceCard.promotion.viewpromo']}}
{{$productOrderCtrl.translations['antibody.pdp.commerceCard.promotion.promocode']}}: {{promo.promoCode}} {{promo.promoTitle}} {{promo.promoDescription}}. {{$productOrderCtrl.translations['antibody.pdp.commerceCard.promotion.learnmore']}}
产品信息
PA5-58900
种属反应
宿主/亚型
分类
类型
抗原
偶联物
形式
浓度
规格
纯化类型
保存液
内含物
保存条件
运输条件
RRID
产品详细信息
Immunogen sequence: GESGEEDPFP SRDPRSLGPM VPSLLTGITL GPPRMESPSG PHRRLGSPQA IEEAASSSSA GPNLGQSG
Highest antigen sequence identity to the following orthologs: Mouse - 46%, Rat - 46%.
靶标信息
Syntrophin is an adapter protein that functions to bind certain signaling molecules to the dystrophin-associated protein complex. This complex connects the extracellular matrix to the intracellular cytoskeleton for construction and maintenance of the postsynaptic structures in the neuromuscular junction and the central nervous system. Microtubule-associated serine/threonine-protein kinase 2 (MAST205) is a testis-specific, cytoplasmic protein that functions in a multi-protein complex in the maturation of spermatids. MAST205 is involved in linking the dystrophin/utrophin network with microtubule filaments via Syntrophin. By forming a complex with TRAF6, MAST205 regulates lipopolysaccharide-induced IL-12 synthesis in macrophages. This leads to the inhibition of TRAF6 NF-kappa-B activation. Two isoforms exist for MAST205 due to alternative splicing. Isoform 1 represents the full length protein, while isoform 2 lacks the residues 327-396 and 1091-1113. The N-terminus of MAST205 must be phosphorylated in order for ubiquitination to occur at the same site. This ubiquitination leads to the degradation of MAST205 via proteasome-mediated proteolysis.
仅用于科研。不用于诊断过程。未经明确授权不得转售。
篇参考文献 (0)
生物信息学
蛋白别名: microtubule associated testis specific serine/threonine protein kinase; Microtubule-associated serine/threonine-protein kinase 2; unnamed protein product
基因别名: KIAA0807; MAST2; MAST205; MTSSK
UniProt ID: (Human) Q6P0Q8
Entrez Gene ID: (Human) 23139